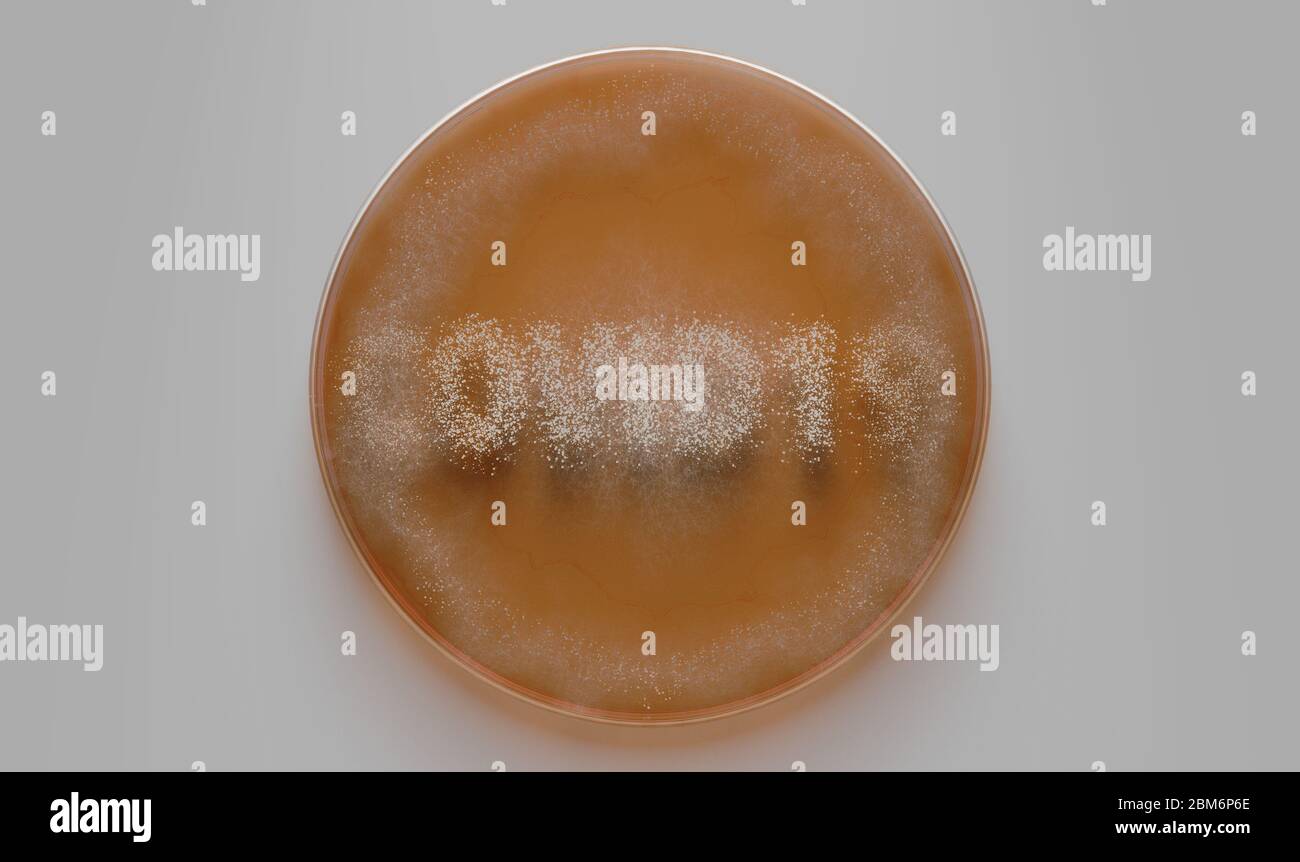
Un concetto che mostra funghi che crescono in un mezzo arancione in un piatto Petri che indica la parola covid-19 - rendering 3D Foto Stock
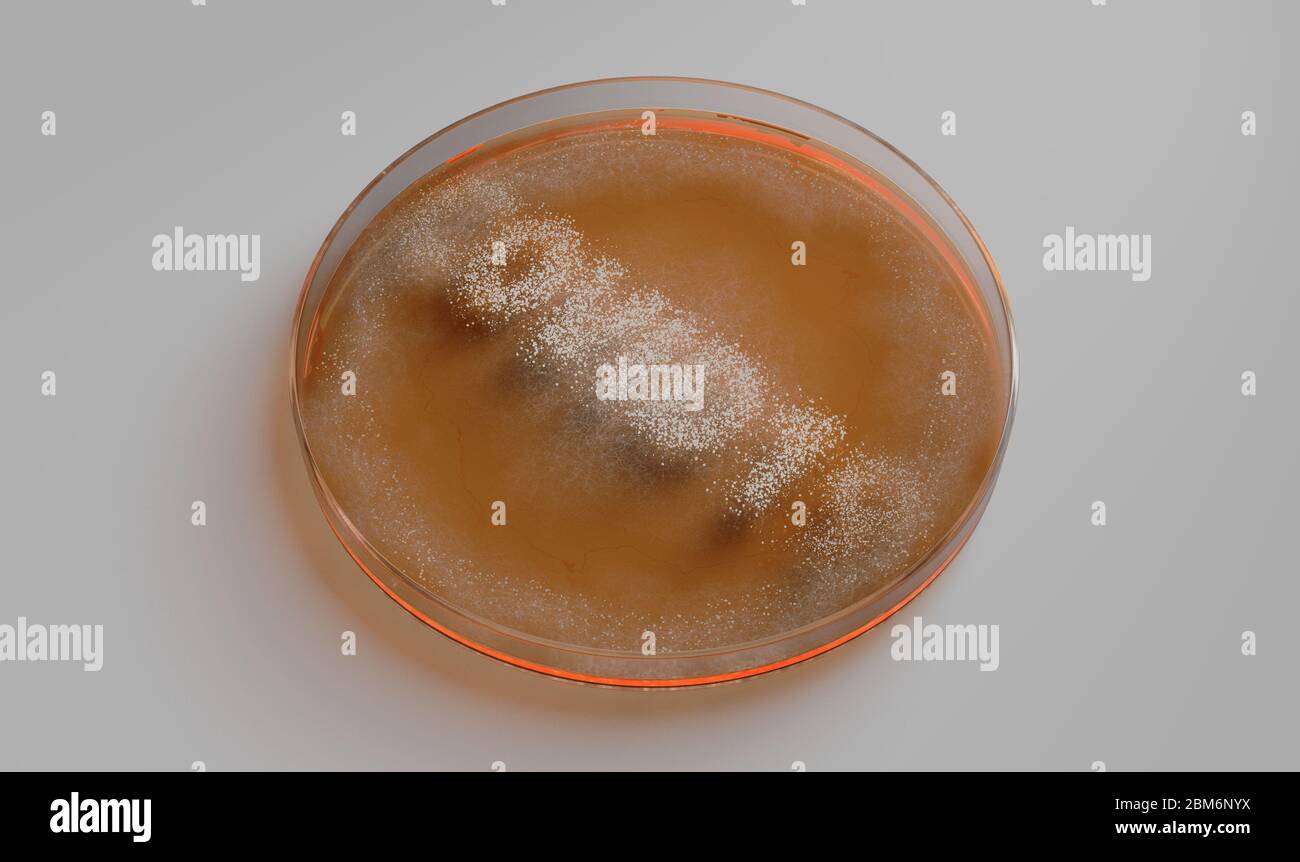
Un concetto che mostra funghi che crescono in un mezzo arancione in un piatto Petri che indica la parola covid-19 - rendering 3D Foto Stock
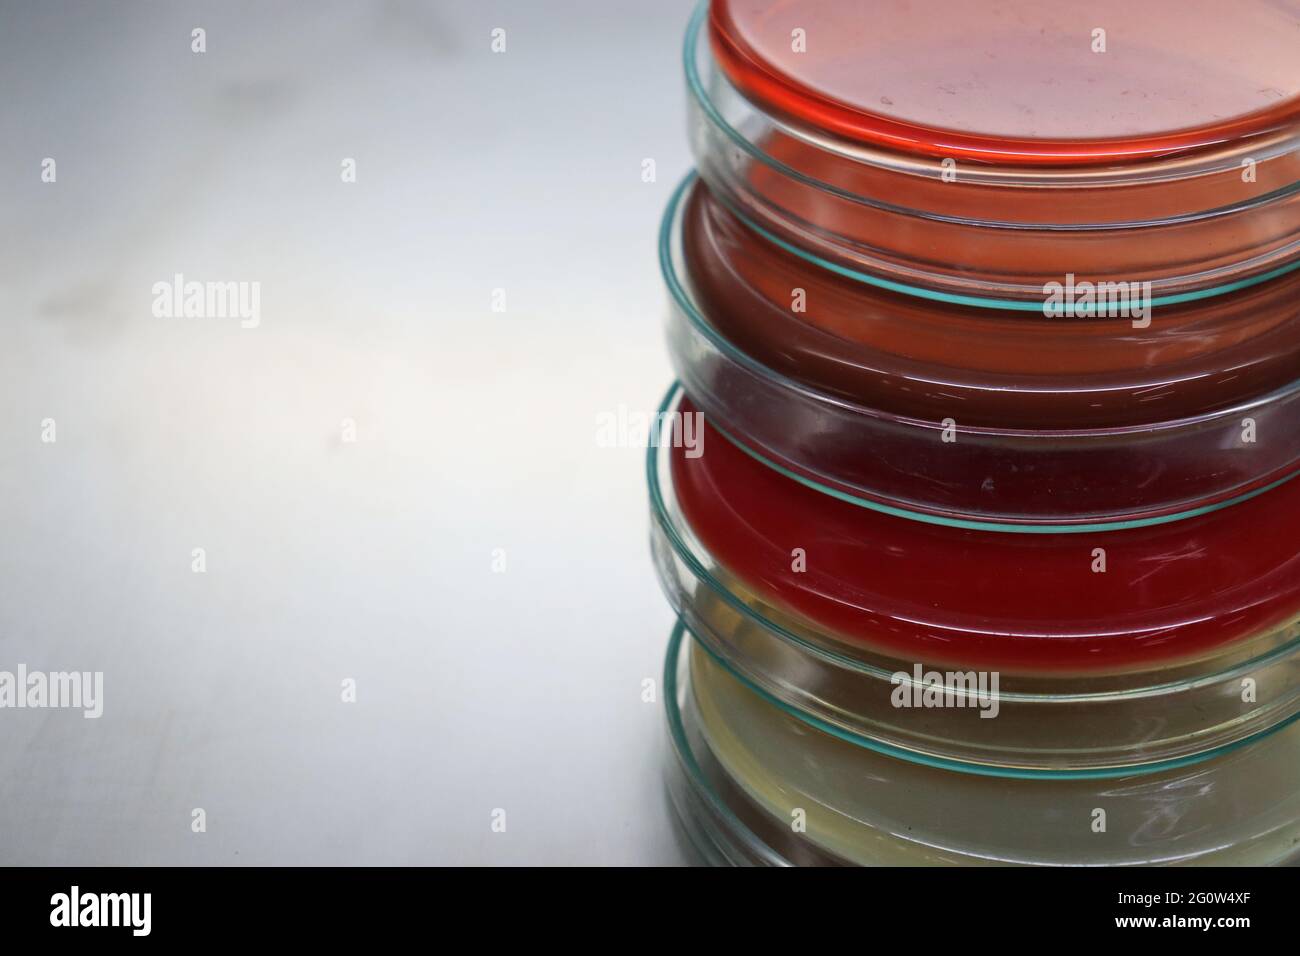
Un mezzo di crescita o terreno di coltura è un solido, liquido o semisolido progettato per supportare la crescita di una popolazione di microrganismi Foto Stock
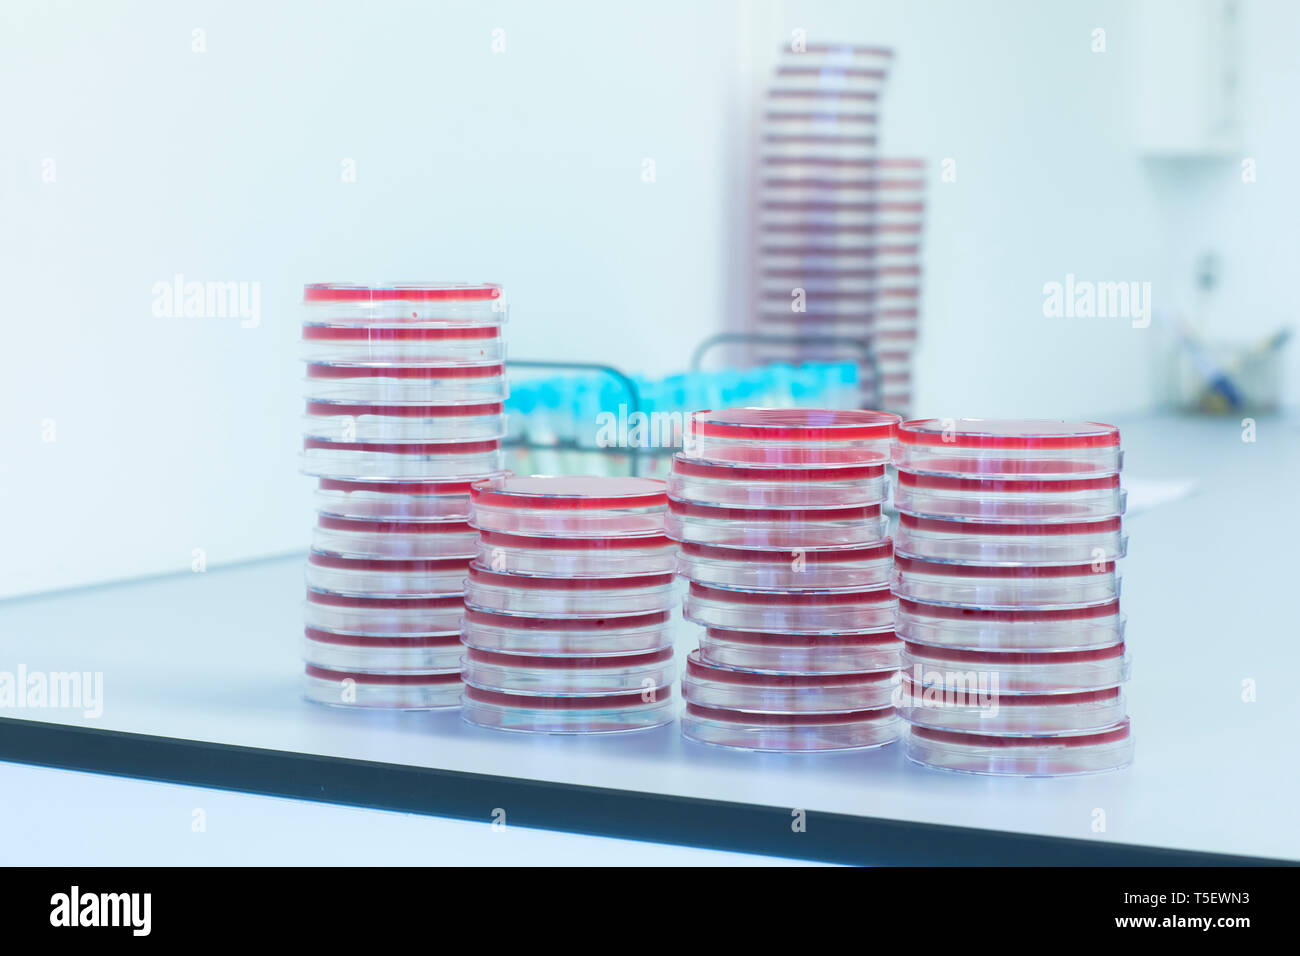
Capsule Petri con terreno di crescita in laboratorio Foto Stock
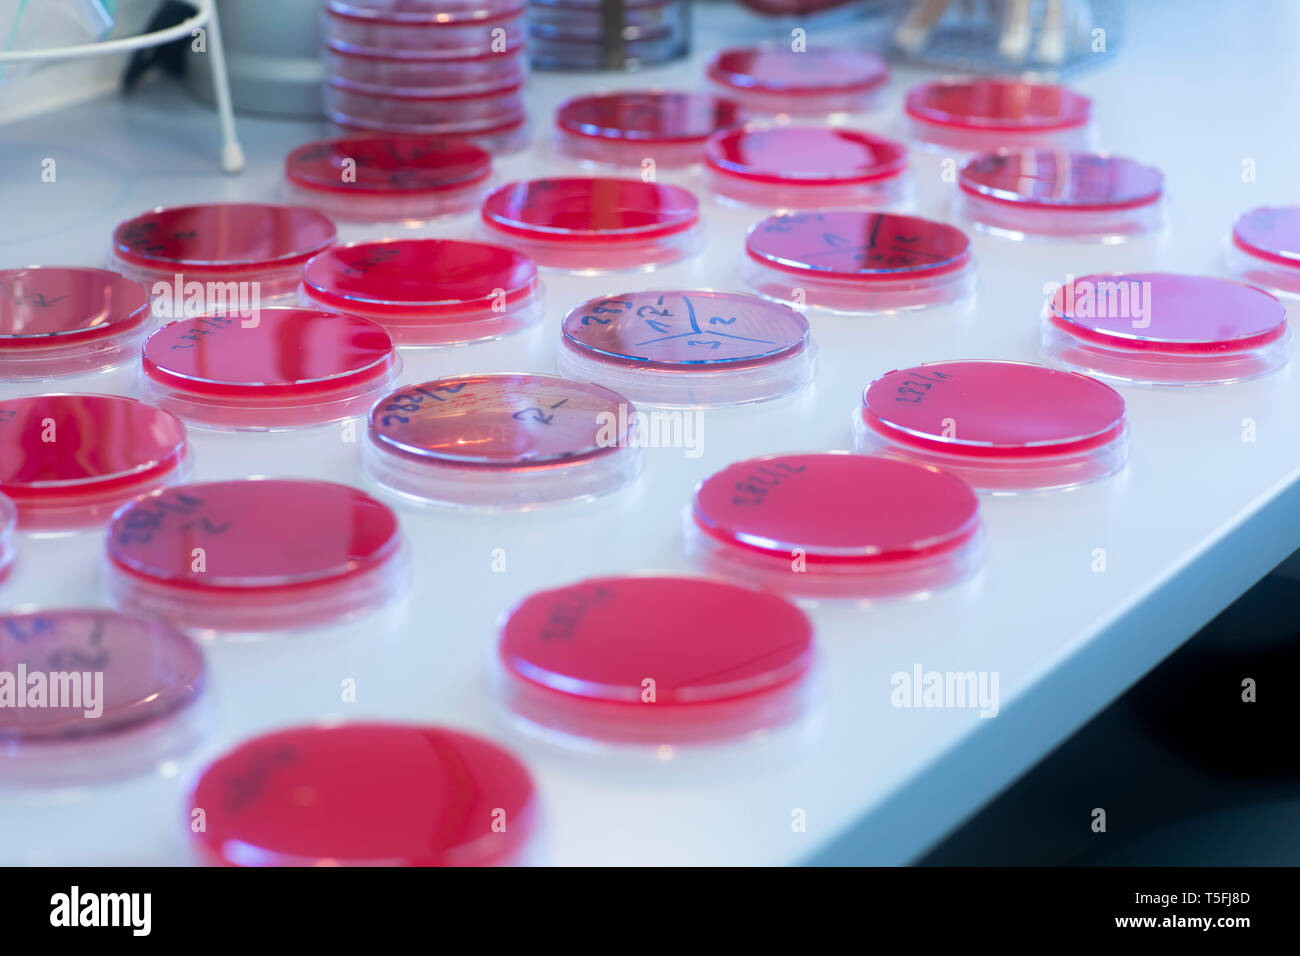
Capsule Petri con terreno di crescita in laboratorio Foto Stock

Mezzo di crescita Immagini Stock
(18,193)Filtri rapidi:
Mezzo di crescita Immagini Stock

RFF0AB2K–La cella femmina biologo azienda pallone contenente cellule staminali, coltivato in rosso medium di crescita

RFF0AB2N–La cella femmina biologo azienda pallone contenente cellule staminali, coltivato in rosso medium di crescita

RFW4GFKN–Cellula umana ricerca, cella femmina biologo esaminando un pallone contenente cellule staminali, coltivato in rosso medium di crescita in laboratorio

RFE0A88D–Biologo cellulare tenendo un pallone contenente cellule staminali, coltivato in rosso medium di crescita, per studiare le malattie

RFRJPPWF–Biologo cellulare tenendo un pallone contenente cellule staminali, coltivato in rosso terreno di crescita in un laboratorio

RMJEC2CG–Africa, Namibia, Namib Desert, con pesci di balena, dune, crescita, medium close-up, dune 7, deserto, sabbia, erosione erosione di vento, crescita, piante, verde, pavimento viticci, colline di sabbia, colline,

RF2K2E45G–Coltura di tessuti di callo vegetale, scienza biologica per rigenerazione vegetale. Terreno di crescita in vitro.

RF2M13G49–Tappeto di canapa, superficie e sfondo, dall'alto. Terreno di crescita per la crescita di microgreens. Fibre industriali e naturali di canapa.

RF2BBN49D–Capsule di Petri con terreno di coltura o terreno di coltura diversi, un solido, liquido o semisolido destinato a sostenere la crescita di microrganismi o cellule,

RF2BM6P32–Un concetto che mostra funghi che crescono in un mezzo arancione in un piatto Petri che indica la parola covid-19 - rendering 3D

RFRYY1EE–Pallone contenente cellule staminali, coltivato in rosso medium di crescita in laboratorio.

RF2ATHED4–Substrato organico di base per coltivazione di funghi, terreno di crescita fungicola, dettagli

RF2K97XCB–Donna vigorosamente spazzolando i capelli dei suoi cani contro il grano. Scatto sfocato in movimento

RFM23CM0–Un background microbiologico fatta di lieviti e di colonie batteriche/culture in un mezzo di crescita.

RFF0AB2J–La cella femmina biologo azienda pallone contenente cellule staminali, coltivato in rosso medium di crescita

RF2G7X9N7–Coltura del tessuto di callo delle piante, scienza di biologia per rigenerazione delle piante. Terreno di crescita in vitro. Varie piante coltivate in vitro in piatti e tubi in

RFW4GGKB–Cellula umana ricerca, cella femmina biologo esaminando un pallone contenente cellule staminali, coltivato in rosso medium di crescita in laboratorio

RFE0A88J–La cella femmina biologo tenendo un pallone contenente cellule staminali, coltivato in rosso medium di crescita, per studiare la malattia

RM2WWB35R–In questa foto del 2019, uno scienziato dei centri per il controllo e la prevenzione delle malattie (CDC) rimuove il terreno di crescita cellulare da una piastra a 6 pozzetti.

RF2HG8K7P–Un muro verde è una struttura verticale costruita intenzionalmente coperta da vegetazione. Le pareti verdi includono un mezzo di crescita applicato verticalmente come suolo.

RF2M3HC9H–Tappeto di coltivazione canapa, superficie, macro, dall'alto. Terreno di crescita per microgreens, in fibre industriali e naturali di canapa.

RF2G0W4WN–l'agar sangue al cioccolato è un mezzo di crescita non selettivo e arricchito utilizzato per l'isolamento di batteri patogeni
RF2BM6P6E–Un concetto che mostra funghi che crescono in un mezzo arancione in un piatto Petri che indica la parola covid-19 - rendering 3D

RFRYY1EG–Pallone contenente cellule staminali, coltivato in rosso medium di crescita in laboratorio.

RF2KFH8WH–3D immagine della formula scheletrica dell'acido deidroascorbico - struttura chimica molecolare dell'acido ascorbico ossidato isolato su sfondo bianco

RMKPKMR1–Stati Uniti d'America, nello Stato di Washington, il Parco Nazionale di Olympic, percorso attraverso la vecchia foresta pluviale di crescita (formato di grandi dimensioni disponibili)

RFF0AB2M–La cella femmina biologo azienda pallone contenente cellule staminali, coltivato in rosso medium di crescita

RFE0A88F–Chiusura del biologo cella tenendo un pallone contenente cellule staminali, coltivato in rosso medium di crescita, per studiare la malattia

RFE0A88H–Close up di cella femmina biologo tenendo un pallone contenente cellule staminali, coltivato in rosso medium di crescita, per studiare la malattia

RFW4GYXF–Cellula umana ricerca, cella femmina biologo esaminando un pallone contenente cellule staminali, coltivato in rosso medium di crescita sotto un microscopio in laboratorio

RF2HG8KGW–Un muro verde è una struttura verticale costruita intenzionalmente coperta da vegetazione. Le pareti verdi includono un mezzo di crescita applicato verticalmente come suolo.

RF2M15F12–Tappeto di coltivazione canapa, superficie e sfondo, primo piano, dall'alto. Terreno di crescita, realizzato con fibre industriali e naturali di canapa.

RF2G0W4YE–Un mezzo di crescita o terreno di coltura è un solido, liquido o semisolido progettato per supportare la crescita di una popolazione di microrganismi
RF2BM6NYX–Un concetto che mostra funghi che crescono in un mezzo arancione in un piatto Petri che indica la parola covid-19 - rendering 3D

RFRYY1ED–Pallone contenente cellule staminali, coltivato in rosso medium di crescita in laboratorio.

RM2WXY0C3–Aumento della domanda di alloggi a Sydney Australia, nuove case costruite a Belleville, parte della regione di crescita del Nord Ovest, NSW, Australia, 2024

RMKPKMPW–Stati Uniti d'America, nello Stato di Washington, il Parco Nazionale di Olympic, percorso attraverso la vecchia foresta pluviale di crescita (formato di grandi dimensioni disponibili)

RMH43JKJ–Foglie di palma, medie di close-up, piante, vegetazione, Palm, Palm professionale, foglie e Washingtonia, campione, linee, struttura sunny, verde, luce, crescita, botanica,

RMEW40MR–Crescita e progresso concetto con tre diversi proprietari. Concetto di tre diversi proprietari.

RF2WR0Y5Y–Uomo d'affari con un grafico in crescita. Crescita del business e risultati dei profitti. Concetto di soddisfazione del cliente

RFH3MY49–Scienziato tenendo una piastra multipozzetto contenente terreno di crescita comunemente utilizzati nella ricerca biologica per mantenere e far crescere le cellule

RFE0A88M–Le mani del biologo cella tenendo un pallone contenente cellule staminali, coltivato in rosso medium di crescita, per studiare la malattia

RFF0ADG3–Visualizzazione dello scienziato stem cell culture in crescita in un mezzo di crescita sotto un microscopio invertito in un laboratorio

RF2HG8KAJ–Un muro verde è una struttura verticale costruita intenzionalmente coperta da vegetazione. Le pareti verdi includono un mezzo di crescita applicato verticalmente come suolo.
RF2G0W4XF–Un mezzo di crescita o terreno di coltura è un solido, liquido o semisolido progettato per supportare la crescita di una popolazione di microrganismi

RF3A510HC–Team di startup diversificato composto da giovani professionisti che collaborano in un ufficio luminoso, discutendo idee durante una riunione con una configurazione a doppio monitor. Ideale per funzioni di lavoro di squadra, luoghi di lavoro moderni e crescita imprenditoriale.

RFRYY1EF–Pallone contenente cellule staminali, coltivato in rosso medium di crescita in laboratorio.

RF2ATHED9–Substrato biologico di fondo per la coltivazione di funghi gourmet, terreno di crescita fungicoltura, panorama

RF2PG29B7–Tre pile di monete, circondate da terreno (terreno in crescita) e nuove foglie di piante verdi (crescita di recupero)

RMKPKC0P–Washington, il Parco Nazionale di Olympic, vista creek nella vecchia foresta pluviale di crescita

RMH43AP6–Amenti, filetti di filatura, medium close-up, Willow Tree, Willow famiglia, dettaglio, ramo, gemme, blossom, crescita, rete di filatura, dewdrop, natura, vegetali,

RFDPAEP5–Pallone con terreno di crescita (agar-medie) è versata in una scatola Petri. La crescita batterica

RF2JM1X35–Primo piano di vermiculite esfoliata, un minerale idrato usato come terreno di coltura senza soilless per le piante

RF2BPK887–shot astratto a telaio intero che mostra molte capsule di petri impilate riempite con terreno di crescita agar colorato

RFF0ADG4–Visualizzazione dello scienziato stem cell culture in crescita in un mezzo di crescita sotto un microscopio invertito in un laboratorio

RFF0ADG5–Visualizzazione dello scienziato stem cell culture in crescita in un mezzo di crescita sotto un microscopio invertito in un laboratorio

RF2HG8KDJ–Un muro verde è una struttura verticale costruita intenzionalmente coperta da vegetazione. Le pareti verdi includono un mezzo di crescita applicato verticalmente come suolo.

RF2G0W4Y4–Un mezzo di crescita o terreno di coltura è un solido, liquido o semisolido progettato per supportare la crescita di una popolazione di microrganismi

RFRYY1EC–Pallone contenente cellule staminali, coltivato in rosso medium di crescita in laboratorio.

RF2ATHEDF–Substrato organico per la coltivazione di funghi, pellets di paglia e acqua calda come mezzo di crescita, spazio di lavoro

RF2PG29AT–Tre pile di monete, circondate da terreno (terreno in crescita) e nuove foglie di piante verdi (crescita di recupero)

RMKPHT6E–Stati Uniti d'America, Oregon, Mt Hood National Forest, vista della cascata e vecchia foresta (formato di grandi dimensioni disponibili)

RMH4A862–Moss, filiali medie close-up, legno, albero, tronco, impianto, natura, esterno, botanica, flora, bemoost, vecchio marcio, dettaglio close up, moss crescita,